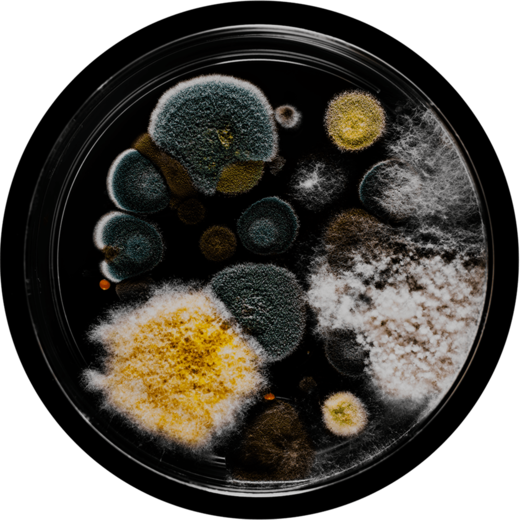
Petrischale
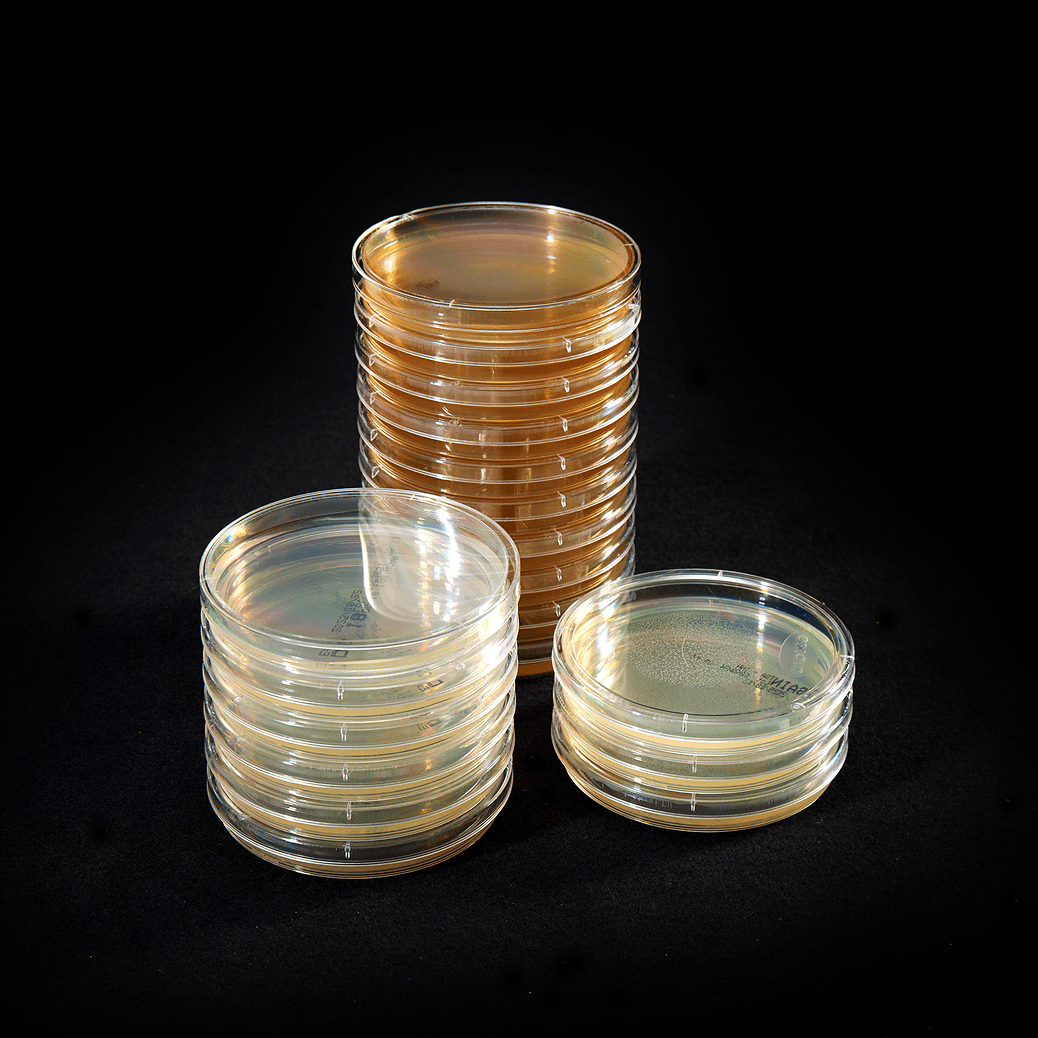
Petrischalen

Analytik
trifft Service.
Noch nie waren Hygieneprüfungen
so einfach.

Fachlabor für
mikrobiologische
Analytik.
Mikrobiologische
Analysen für VDI 6022
Hygieneinspektionen.
Deutschlands erstes
VDI 6022 zertifiziertes Labor.
Mikrobiologische
Analysen für die
Umgebungsüberwachung
in der Lebensmittelbranche.
Analysen für die
Umgebungsüberwachung
in der Lebensmittelbranche.

Mikrobiologische Analysen
für Krankenhaushygiene,
GMP und Reinraumtechnik.

Mikrobiologische Analysen
von Schimmelpilzen in
Innenräumen.
Akkreditierung durch die
Deutsche Akkreditungsstelle.

Millionen
Bakterien,
Mikroben
& Pilze.
Ach ja,
ein paar
Menschen
auch.
Bakterien,
Mikroben
& Pilze.
Ach ja,
ein paar
Menschen
auch.
Geschäftsführung + Laborleitung

Dr.
Mara
Pop
Leitung Forschung + Entwicklung

Dr.
Matthew
Copping
Stellvertretende Laborleitung

Stefanie
Haag
Unsere Kooperationen

Wir sind Mitglied
folgender Verbände: